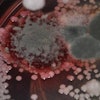
Rock-River-Laboratory-TMR-Hygiene-diagnostic-package
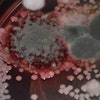
Rock River Laboratory Tmr Hygiene Diagnostic Package

Rock River Laboratory, Inc.
Watertown, WI 53094
Rock River Laboratory is a family-owned laboratory network that partners with their customers to serve the living and growing needs of the agriculture industry through analysis of feedstuffs, soil, plant tissue, water, and much more. Founded in 1976, Rock River Laboratory has spent the last 41 years equipping the agriculture industry with the tools and answers they need to make decisions for successful outcomes. Their team consists of top specialists in their respective fields to help the laboratory provide accurate, cost-effective, and timely analytical results to customers worldwide. Progress for the benefit of the industry and unwavering customer service guides Rock River Laboratory’s business's decisions and actions as they continue to build, test and offer products and services that revolve around the end-user: their customers.